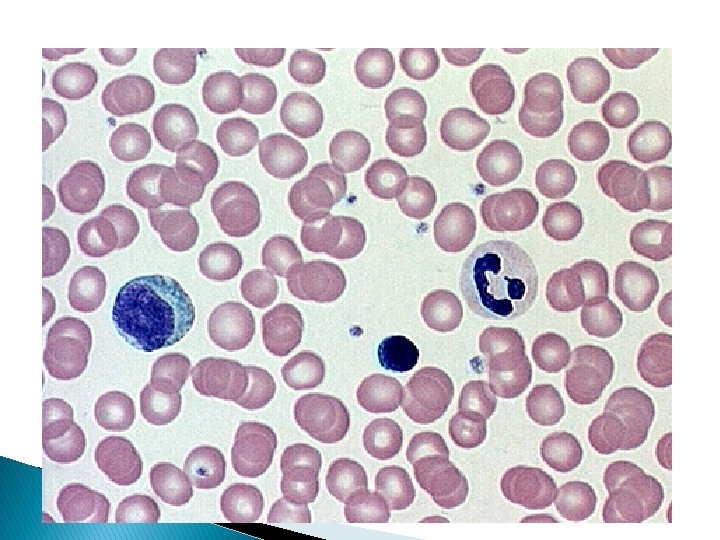

Body Tissues Four Main Types of Body Tissues

Body Tissues

Four Main Types of Body Tissues • Sometimes I refer to them as basic tissue types • Epithelium • Connective • Muscular • Nervous

Epithelium �Lining, covering, and glandular tissue of the body. �Functions: ◦ Protection ◦ Absorption ◦ Filtration ◦ Secretion

Special Characteristics of Epithelium � Fits closely together to form continuous sheets. � Membranes always have one free, unattached surface. ◦ Apical surface � Lower surface of the epithelium rests on the basement membrane. � No blood supply of their own. (depend on diffusion)

Types of Epithelium � Simple- one layer of cells � Stratified- more than one layer of cells. � Pseudostratified- single layer, but appears stratified because some cells are shorter than others.


Simple Squamous � Single layer of thin squamous cells � On a basement membrane � Fit closely together � Usually found where filtration or exchange of substances occurs.


Stratified Squamous � Most common stratified epithelium in the body � Several layers of squamous cells � Cells closest to free edge are squamous shaped, but those closest to the basement membrane appear cuboidal. � Found in cites that receive a lot of abuse or friction ◦ Esophagus, mouth, outer portion of the skin


Simple Cuboidal � One � On layer of cuboidal cells a basement membrane � Common � Walls in glands and ducts of kidneys, surface of ovaries


Stratified Cuboidal � At least two layers of cuboidal cells � Rare in the body � Found mainly in the ducts of large glands


Simple Columnar � Single � Lines layer of tall cells that fit closely together. entire length of digestive tract � Goblet cells-produce lubricating mucus are often seen here. � Mucosae (mucous membranes)- epithelial membranes that line body cavities open to the body exterior


Stratified Columnar � Surface cells are columnar � Basal cells vary in size and shape. � Fairly rare in the body � Found mainly in the ducts of large glands.


Pseudostratified Columnar � Single layer of cells � Some cells are shorter than others, making nuclei appear at different heights. � Functions in absorption and secretion. � Ciliated pseudostratified are found in the respiratory tract. ◦ Cilia propel mucus upward and away from the lungs


Transitional � Highly modified � Stratified � Basal � In squamous epithelium layer cells are cuboidal or columnar urinary system


Connective Tissue � Connects � Found � Most � Well body parts everywhere in the body abundant and widely spread tissue type vascularized, has its own blood supply. � Extracellular matrix- nonliving substance found outside the cells.

Types of Connective Tissue All composed of cells surrounded by a matrix. The major difference reflect the number and types of fibers in the matrix. Bone Cartilage (hyaline & elastic) Adipose Loose Areolar Connective Blood

Matrix � Matrix is what makes connective tissues different from other tissues. � Produced by connective tissue cells and secreted outside of the cell. � Composed � Because of water and proteins of its matrix, connective tissue is able to form soft packing tissue around other organs to bear weight and withstand abuse.

Bone � Osseous tissue � Composed of bone cells (osteocytes) sitting in cavities called lacunae � Surrounded � Protect by layers of a hard matrix and support other body organs


Hyaline Cartilage � Most � Less � Has widespread cartilage hard and more flexible than bone. abundant collagen fibers � Glassy � Found matrix in larynx, attaches ribs to breastbone, covers the end of bones where joints form.


Elastic Cartilage �Less hard and more flexible than bone. �Found where elasticity is desired. �Supports external ear


Fibrocartilage �Forms the cushion-like disks between the vertebrae of the spinal column

Areolar Tissue � Most widely distributed connective tissue in the body. � Soft, pliable, cobwebby tissue � Cushions � Helps and protects body organs hold internal organs together


Adipose Tissue � Fat tissue � Oil occupies most of a fat cell’s volume and pushes the nucleus to the side � Forms subcutaneous tissue beneath the skin. � Insulates and cold. the body and protects it from heat


Blood � Vascular tissue � Consists of blood cells surrounded by a nonliving matrix called plasma � Transport system. vehicle for the cardiovascular

Connective Tissue- WBC � White Blood Cells (WBCs) � Granulocytes – granules in their cytoplasm � Agranulocutes� Leucocytes ◦ ◦ ◦ Neutrophils Eosinophils Basophils Lymphocytes Monocytes no granules in their cytoplasm

Neutrophils- Granulocytes � Neutrophils – most numerous WBC ◦ Phagocytize and destroy bacteria ◦ Nucleus – has two to six lobes ◦ Granules pick up acidic and basic stains Figure 17. 4 a

Eosinophils- Granulocytes � Eosinophils – compose 1 – 4% of all WBCs ◦ Play roles in ending allergic reactions, parasitic infections Figure 17. 4 b

Basophils- Granulocytes � Basophils – about 0. 5% of all leukocytes ◦ Nucleus – usually two lobes ◦ Granules secrete histamines ◦ Function in inflammation mediation, similar in function to mast cells

Lymphocytes- Agranulocytes � Lymphocytes ◦ ◦ – compose 20 – 45% of WBCs The most important cells of the immune system Nucleus – stains dark purple Effective in fighting infectious organisms Act against a specific foreign molecule (antigen) � Two main classes of lymphocyte ◦ T cells – attack foreign cells directly ◦ B cells – multiply to become plasma cells that secrete antibodies Figure 17. 4 d

Monocytes- Agranulocytes � Monocytes – compose 4– 8% of WBCs ◦ The largest leukocytes ◦ Nucleus – kidney shaped ◦ Transform into macrophages �Phagocytic cells Figure 17. 4 e

Muscular Tissue � Highly specialized to contract or shorten to produce movement � Muscle fibers cells are elongated and therefore called

Skeletal Muscle � Packaged skeleton. � Can by connective tissue sheets attached to the be controlled- voluntary � Form the flesh of the body � The result of their action is gross body movements or changes in facial expressions. � Cells are long, cylindrical, multinucleate, and have striations (stripes)


Smooth Muscle � Visceral � No muscle striations are visible � Single nucleus and are spindle shaped (pointed at each � Found in the walls of hallow organs end) � When smooth muscle contracts the cavity of the organ becomes smaller(constricts) or enlarges(dilates) � Peristalsis- food moving through the small intestine – muscle contracting in a wavelike motion


Cardiac Muscle � Found � Has only in the heart striations � Uninucleate � Branching � Fit tightly together at gap junctions called intercalated disks. � Involuntary


Nervous Tissue � All neurons receive and transmit electrochemical impulses from one part of the body to another.

- Slides: 53